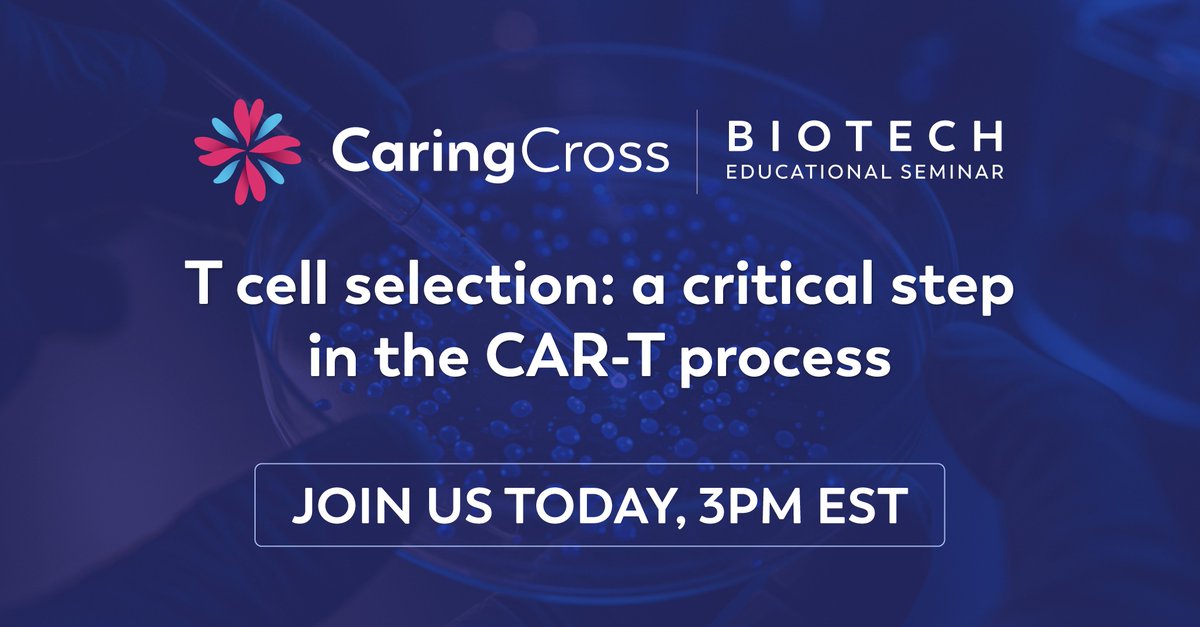
🔬 Biotech Seminar – Today!
T Cell Selection: A Critical Step in the CAR-T Process
Presenter: Dr. Kevin Curran, PhD

🔗 Register: ow.ly/pizV50W5FV3

#CARTtherapy #BiotechWebinar #CellTherapy #TCellSelection #HealthEquity #PatientAccess #CAR_T #Immunotherapy

Caring Cross
@caring_cross
Imagine a world without disease. Let's join forces to accelerate the development of advanced medicines and ensure access to cures for all patients, everywhere.
ID: 1269035721924501505
http://caringcross.org 05-06-2020 22:38:22
809 Tweet
7,7K Takipçi
124 Takip Edilen














Thank you to everyone who joined today’s “Unlocking Next-Gen Therapies” event! Grateful to Friends of Cancer Research & @ParkerICI for organizing, and to the incredible panelists for an insightful discussion. Missed it? youtube.com/watch?v=hkQfiG… #CellTherapy #HealthEquity #AccessForAll